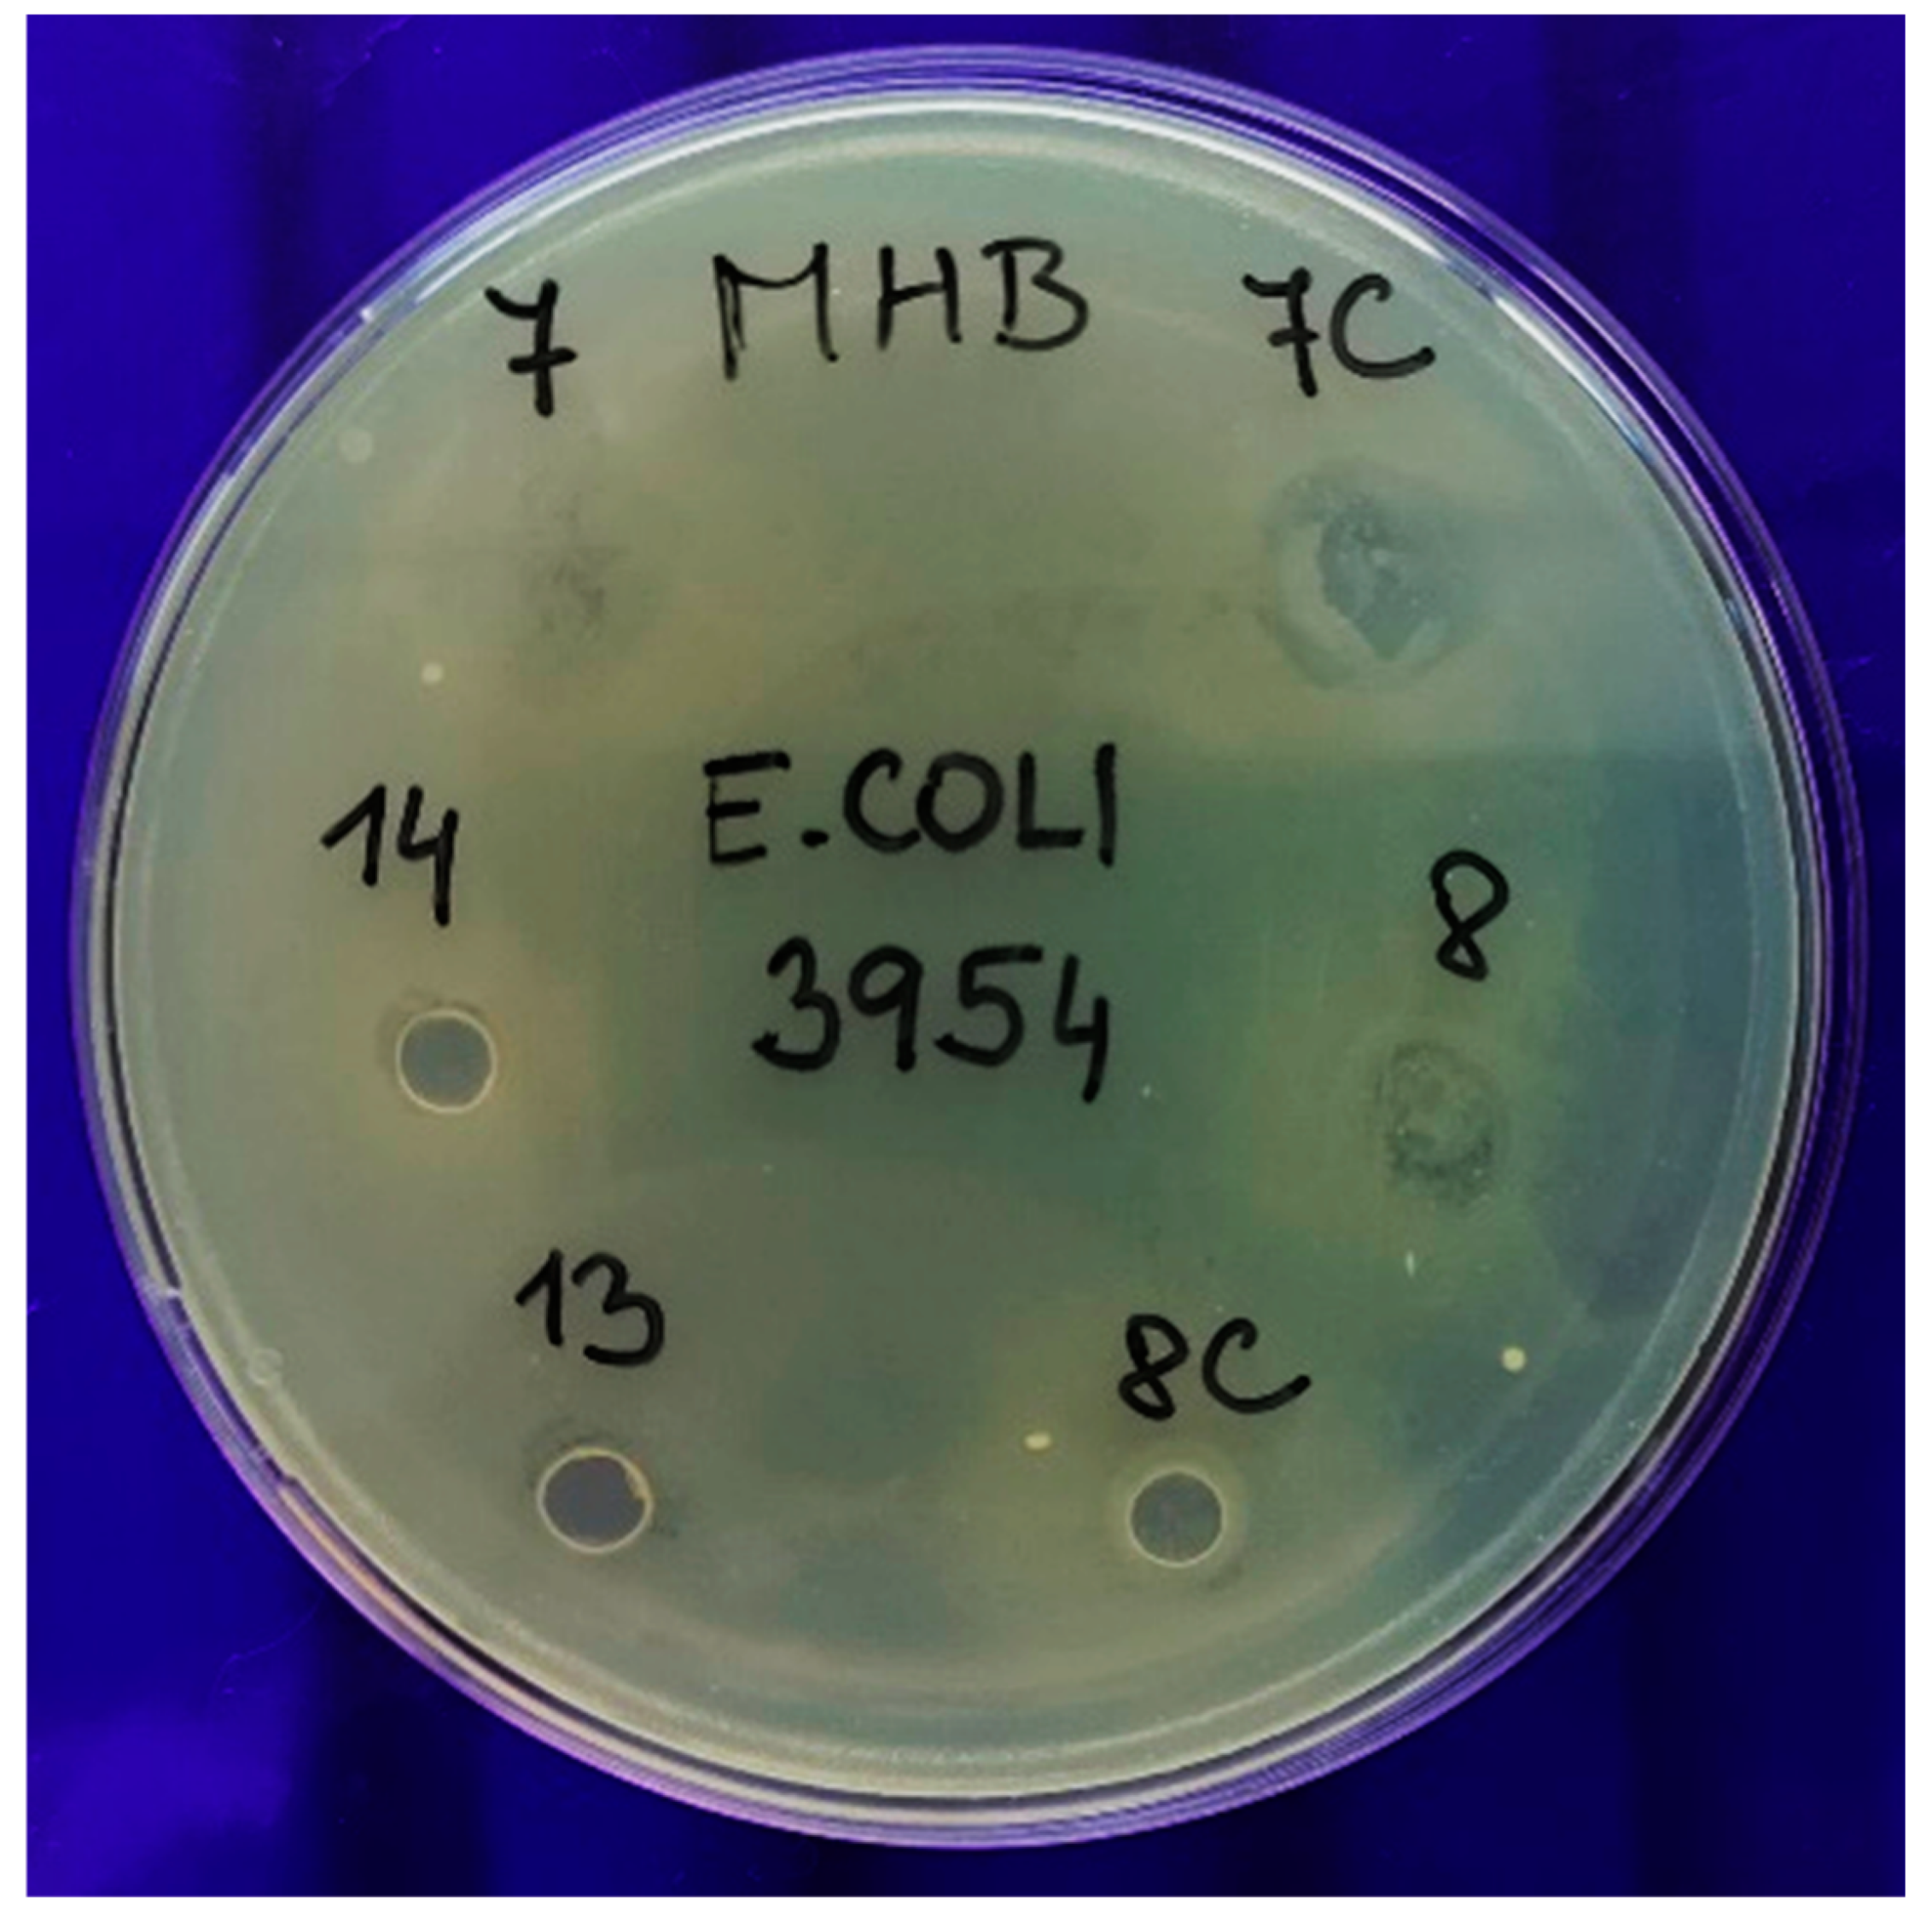
Polymers 13 00332 g011 Polymers 13 00332 g011

Edible Films from Carrageenan/Orange Essential Oil/Trehalose—Structure, Optical Properties, and Antimicrobial Activity
Abstract
1. Introduction
2. Materials and Methods
2.1. Material and Preparation of Edible Films
2.2. UV-Vis Spectra and Transparency Value
2.3. Attenuated Total Reflectance Fourier-Transform Spectroscopy
2.4. Scanning Electron Microscopy
2.5. Antimicrobial Activity
2.6. Statistical Analysis
3. Results and Discussion
3.1. UV-Vis Spectra
3.2. Transmittance
3.3. Transparency Value
3.4. Scanning Electron Microscopy
3.5. Fourier-Transform Infrared Spectroscopy
3.6. Antimicrobial Activity
3.7. Principal Component Analysis
4. Conclusions
Supplementary Materials
Author Contributions
Funding
Conflicts of Interest
References
- Lee, D.S.; Yam, K.L.; Piergiovanni, L. Food Packaging Science and Technology; CRC Press: Boca Raton, FL, USA, 2008. [Google Scholar]
- Ramos, Ó.L.; Reinas, I.; Silva, S.I.; Fernandes, J.C.; Cerqueira, M.A.; Pereira, R.N.; Vicente, A.A.; Poças, M.F.; Pintado, M.E.; Malcata, F.X. Effect of whey protein purity and glycerol content upon physical properties of edible films manufactured therefrom. Food Hydrocoll. 2013, 30, 110–122. [Google Scholar] [CrossRef]
- Ramos, M.; Valdes, A.; Beltran, A.; Garrigós, M.C. Gelatin-based films and coatings for food packaging applications. Coatings 2016, 6, 41. [Google Scholar] [CrossRef]
- Wang, Z.; Tang, L.; Lin, F.; Shen, Y.; Chen, Y.; Chen, X.; Huang, B.; Lu, B. Multi-Functional Edible Film with Excellent UV Barrier Performance and Accurate Instant Ion Printing Capability. Adv. Sustain. Syst. 2020, 4, 1–10. [Google Scholar] [CrossRef]
- Farajpour, R.; Djomeh, Z.E.; Moeini, S.; Tavahkolipour, H.; Safayan, S. Structural and physico-mechanical properties of po-tato starch-olive oil edible films reinforced with zein nanoparticles. Int. J. Biol. Macromol. 2020, 149, 941–950. [Google Scholar] [CrossRef]
- Bourtoom, T. Edible films and coatings: Characteristics and properties. Int. Food Res. J. 2008, 15, 237–248. [Google Scholar]
- Albanese, D.; Cinquanta, L.; Di Matteo, M. Effects of an innovative dipping treatment on the cold storage of minimally processed Annurca apples. Food Chem. 2007, 105, 1054–1060. [Google Scholar] [CrossRef]
- Yildiz, F.; Wiley, R.C. Minimally Processed Refrigerated Fruits and Vegetables; Springer: New York, NY, USA, 2017. [Google Scholar]
- Ayhan, Z. Packaging and Preservation Methods of Minimally Processed Produce. In Agents of Change; Springer: New York, NY, USA, 2017; Volume 89, pp. 239–268. [Google Scholar]
- Richards, A.; Krakowka, S.; Dexter, L.; Schmid, H.; Wolterbeek, A.; Waalkens-Berendsen, D.; Shigoyuki, A.; Kurimoto, M. Trehalose: A review of properties, history of use and human tolerance, and results of multiple safety studies. Food Chem. Toxicol. 2002, 40, 871–898. [Google Scholar] [CrossRef]
- Liu, T.; Zhu, L.; Zhang, Z.; Huang, H.; Zhang, Z.; Jiang, L. Protective role of trehalose during radiation and heavy metal stress in Aureobasidium subglaciale F134. Sci. Rep. 2017, 7, 17586. [Google Scholar] [CrossRef]
- Lv, F.; Liang, H.; Yuan, Q.; Li, C. In vitro antimicrobial effects and mechanism of action of selected plant essential oil com-binations against four food-related microorganisms. Food Res. Int. 2011, 44, 3057–3064. [Google Scholar] [CrossRef]
- Maisanaba, S.; Llana-Ruiz-Cabello, M.; Gutiérrez-Praena, D.; Pichardo, S.; Puerto, M.; Prieto, A.I.; Cameán, A.M. New ad-vances in active packaging incorporated with essential oils or their main components for food preservation. Food Rev. Int. 2017, 33, 447–515. [Google Scholar] [CrossRef]
- Pelissari, F.M.; Grossmann, M.V.; Yamashita, F.; Pineda, E.A.G. Antimicrobial, mechanical, and barrier properties of cas-sava starch− chitosan films incorporated with oregano essential oil. J. Agric. Food Chem. 2009, 57, 7499–7504. [Google Scholar] [CrossRef]
- Sánchez-González, L.; Vargas, M.; González-Martínez, C.; Chiralt, A.; Cháfer, M. Use of Essential Oils in Bioactive Edible Coatings: A Review. Food Eng. Rev. 2011, 3, 1–16. [Google Scholar] [CrossRef]
- Kaur, C.D.; Saraf, S. In vitro sun protection factor determination of herbal oils used in cosmetics. Pharmacogn. Res. 2010, 2, 22–25. [Google Scholar]
- Frassinetti, S.; Caltavuturo, L.; Cini, M.; Della Croce, C.M.; Maserti, B.E. Antibacterial and antioxidant activity of essential oils from Citrus spp. J. Essent. Oil Res. 2011, 23, 27–31. [Google Scholar] [CrossRef]
- Sabo, B.; Bečica, T.; Keleš, N.; Kovačević, D.; Brozović, M. The impact of packaging transparency on product attractiveness. J. Graph. Eng. Des. 2017, 8, 5. [Google Scholar] [CrossRef]
- Cagri, A.; Ustunol, Z.; Ryser, E.T. Antimicrobial Edible Films and Coatings. J. Food Prot. 2004, 67, 833–848. [Google Scholar] [CrossRef] [PubMed]
- Escamilla-García, M.; Calderón-Domínguez, G.; Chanona-Pérez, J.J.; Mendoza-Madrigal, A.G.; Di Pierro, P.; García-Almendárez, B.E.; Amaro-Reyes, A.; Regalado-González, C. Physical, Structural, Barrier, and Antifungal Characterization of Chitosan–Zein Edible Films with Added Essential Oils. Int. J. Mol. Sci. 2017, 18, 2370. [Google Scholar] [CrossRef]
- Siracusa, V.; Romani, S.; Gigli, M.; Mannozzi, C.; Cecchini, J.P.; Tylewicz, U.; Lotti, N. Characterization of Active Edible Films based on Citral Essential Oil, Alginate and Pectin. Materials 2018, 11, 1980. [Google Scholar] [CrossRef]
- Du, W.X.; Avena-Bustillos, R.J.; Hua, S.S.T.; McHugh, T.H. Antimicrobial volatile essential oils in edible films for food safety. Sci. Against Microb. Pathog. Commun. Curr. Res. Technol. Adv. 2011, 2, 1124–1134. [Google Scholar]
- Han, J.H.; Floros, J.D. Casting Antimicrobial Packaging Films and Measuring Their Physical Properties and Antimicrobial Activity. J. Plast. Film Sheeting 1997, 13, 287–298. [Google Scholar] [CrossRef]
- Shankar, S.; Rhim, J.W. Preparation and characterization of agar/lignin/silver nanoparticles composite films with ultravio-let light barrier and antibacterial properties. Food Hydrocoll. 2017, 71, 76–84. [Google Scholar] [CrossRef]
- Ahmed, J.; Arfat, Y.A.; Al-Attar, H.; Auras, R.; Ejaz, M. Rheological, structural, ultraviolet protection and oxygen barrier properties of linear low- density polyethylene films reinforced with zinc oxide (ZnO) nanoparticles. Food Packag. Shelf Life 2017, 13, 20–26. [Google Scholar] [CrossRef]
- Jancikova, S.; Dordevic, D.; Jamroz, E.; Behalova, H.; Tremlova, B. Chemical and Physical Characteristics of Edible Films, Based on κ- and ι-Carrageenans with the Addition of Lapacho Tea Extract. Foods 2020, 9, 357. [Google Scholar] [CrossRef] [PubMed]
- Wu, J.; Sun, X.; Guo, X.; Ge, S.; Zhang, Q. Physicochemical properties, antimicrobial activity and oil release of fish gelatin films incorporated with cinnamon essential oil. Aquac. Fish. 2017, 2, 185–192. [Google Scholar] [CrossRef]
- Ploypetchara, T.; Gohtani, S. Characteristics of rice starch film blended with sugar (trehalose/allose) and oil (canola oil/coconut oil): Part I—Filmogenic solution behavior and mechanical properties. J. Food Sci. 2020, 85, 3372–3379. [Google Scholar] [CrossRef]
- Haghighi, H.; Biard, S.; Bigi, F.; De Leo, R.; Bedin, E.; Pfeifer, F.; Siesler, H.W.; Licciardello, F.; Pulvirenti, A. Comprehensive characterization of active chitosan-gelatin blend films enriched with different essential oils. Food Hydrocoll. 2019, 95, 33–42. [Google Scholar] [CrossRef]
- Liu, Y.; Qin, Y.; Bai, R.; Zhang, X.; Yuan, L.; Liu, J. Preparation of pH-sensitive and antioxidant packaging films based on κ-carrageenan and mulberry polyphenolic extract. Int. J. Biol. Macromol. 2019, 134, 993–1001. [Google Scholar] [CrossRef]
- Zavala, J.A.; Ravetta, D.A. The effect of solar UV-B radiation on terpenes and biomass production in Grindelia chiloensis (Asteraceae), a woody perennial of Patagonia, Argentina. Plant. Ecol. 2002, 161, 185–191. [Google Scholar] [CrossRef]
- Bekbölet, M. Light Effects on Food. J. Food Prot. 1990, 53, 430–440. [Google Scholar] [CrossRef]
- Forney, L.J.; Moraru, C.I. Ultraviolet Light in Food Technology: Principles and Applications; CRC Press: Boca Raton, FL, USA, 2009. [Google Scholar]
- El-Tinay, A.H.; Chichester, C.O. Oxidation of beta-carotene. Site of initial attack. J. Org. Chem. 1970, 35, 2290–2293. [Google Scholar] [CrossRef]
- Rincón, E.; Serrano, L.; Balu, A.M.; Aguilar, J.J.; Luque, R.; García, A. Balu Effect of Bay Leaves Essential Oil Concentration on the Properties of Biodegradable Carboxymethyl Cellulose-Based Edible Films. Materials 2019, 12, 2356. [Google Scholar] [CrossRef] [PubMed]
- Nowicki, M.; Richter, A.; Wolf, B.; Kaczmarek, H. Nanoscale mechanical properties of polymers irradiated by UV. Polymer 2003, 44, 6599–6606. [Google Scholar] [CrossRef]
- Diepens, M.; Gijsman, P. Photodegradation of bisphenol A polycarbonate. Polym. Degrad. Stab. 2007, 92, 397–406. [Google Scholar] [CrossRef]
- Yousif, E.; Haddad, R. Photodegradation and photostabilization of polymers, especially polystyrene: Review. SpringerPlus 2013, 2, 1–32. [Google Scholar] [CrossRef] [PubMed]
- Nor, M.H.M.; Nazmi, N.N.M.; Sarbon, N.M. Effects of plasticizer concentrations on functional properties of chicken skin gelatin films. Int. Food Res. J. 2017, 24, 1910–1918. [Google Scholar]
- Šuput, D.; Lazić, V.; Pezo, L.; Markov, S.; Vaštag, Ž.; Popović, L.; Radulović, A.; Ostojić, S.; Zlatanović, S.; Popović, S. Charac-terization of starch edible films with different essential oils addition. Pol. J. Food Nutr. Sci. 2016, 66, 277–286. [Google Scholar] [CrossRef]
- Shojaee-Aliabadi, S.; Hosseini, H.; Mohammadifar, M.A.; Mohammadi, A.; Ghasemlou, M.; Ojagh, S.M.; Hosseini, S.M.; Khaksar, R. Characterization of antioxidant-antimicrobial κ-carrageenan films containing Satureja hortensis essential oil. Int. J. Biol. Macromol. 2013, 52, 116–124. [Google Scholar] [CrossRef]
- Gómez-Guillén, M.D.C.; Ihl, M.; Bifani, V.; Silva, A.; Montero, P. Edible films made from tuna-fish gelatin with antioxidant extracts of two different murta ecotypes leaves (Ugni molinae Turcz). Food Hydrocoll. 2007, 21, 1133–1143. [Google Scholar] [CrossRef]
- Edhirej, A.; Sapuan, S.M.; Jawaid, M.; Zahari, N.I. Effect of various plasticizers and concentration on the physical, thermal, mechanical, and structural properties of cassava-starch-based films. Starch Stärke 2016, 69, 1500366. [Google Scholar] [CrossRef]
- Ortiz-Tafoya, M.; Tecante, A. Physicochemical characterization of sodium stearoyl lactylate (SSL), polyoxyethylene sorbitan monolaurate (Tween 20) and κ-carrageenan. Data Brief. 2018, 19, 642–650. [Google Scholar] [CrossRef]
- Sussich, F.; Urbani, R.; Princivalle, F.; Cesàro, A. Polymorphic Amorphous and Crystalline Forms of Trehalose. J. Am. Chem. Soc. 1998, 120, 7893–7899. [Google Scholar] [CrossRef]
- Akao, K.-I.; Okubo, Y.; Asakawa, N.; Inoue, Y.; Sakurai, M. Infrared spectroscopic study on the properties of the anhydrous form II of trehalose. Implications for the functional mechanism of trehalose as a biostabilizer. Carbohydr. Res. 2001, 334, 233–241. [Google Scholar] [CrossRef]
- Cooper, J.M.; Tian, W.U.S. Edible Compositions Containing Trehalose. U.S. Patent 6,620,791, 16 September 2003. [Google Scholar]
- Pérez, L.; Piccirilli, G.; Delorenzi, N.J.; Verdini, R. Effect of different combinations of glycerol and/or trehalose on physical and structural properties of whey protein concentrate-based edible films. Food Hydrocoll. 2016, 56, 352–359. [Google Scholar] [CrossRef]
- Aldous, B.J.; Auffret, A.D.; Franks, F. The crystallisation of hydrates from amorphous carbohydrates). Cryoletters 1995, 16, 181–186. [Google Scholar]
- Elbein, A.D.; Pan, Y.; Pastuszak, I.; Carroll, D. New insights on trehalose: A multifunctional molecule. Glycobiology 2003, 13, 17–27. [Google Scholar] [CrossRef] [PubMed]

| Sample | Composition |
|---|---|
| c | 0.5 g κ-carrageenan + glycerol |
| OT80 | 0.5 g κ-carrageenan + tween 80 + orange essential oil + glycerol |
| OT20 | 0.5 g κ-carrageenan + tween 20 + orange essential oil + glycerol |
| Tr0.5 | 0.5 g κ-carrageenan + 0.5% trehalose + glycerol |
| Tr0.5OT80 | 0.5 g κ-carrageenan + 0.5% trehalose + tween 80 + orange essential oil + glycerol |
| Tr0.5OT20 | 0.5 g κ-carrageenan + 0.5% trehalose + tween 20 + orange essential oil + glycerol |
| Tr1 | 0.5 g κ-carrageenan + 1% trehalose + glycerol |
| Tr1OT80 | 0.5 g κ-carrageenan + 1% trehalose + tween 80 + orange essential oil + glycerol |
| Tr1OT20 | 0.5 g κ-carrageenan + 1% trehalose + tween 20 + orange essential oil + glycerol |
| Tr3 | 0.5 g κ-carrageenan + 3% trehalose + glycerol |
| Tr3OT80 | 0.5 g κ-carrageenan + 3% trehalose + tween 80 + orange essential oil + glycerol |
| Tr3OT20 | 0.5 g κ-carrageenan + 3% trehalose + tween 20 + orange essential oil + glycerol |
| 0.3g c | 0.3 g κ-carrageenan + glycerol |
| 0.3gOT80 | 0.3 g κ-carrageenan + tween 80 + orange essential oil + glycerol |
| 0.3gOT20 | 0.3 g κ-carrageenan + tween 20 + orange essential oil + glycerol |
| 0.3gTr0.5 | 0.3 g κ-carrageenan + 0.5% trehalose + glycerol |
| 0.3gTr0.5OT80 | 0.3 g κ-carrageenan + 0.5% trehalose + tween 80 + orange essential oil + glycerol |
| 0.3gTr0.5OT20 | 0.3 g κ-carrageenan + 0.5% trehalose + tween 20 + orange essential oil + glycerol |
| 0.3gTr1 | 0.3 g κ-carrageenan + 1% trehalose + glycerol |
| 0.3gTr1OT80 | 0.3 g κ-carrageenan + 1% trehalose + tween 80 + orange essential oil + glycerol |
| 0.3gTr1OT20 | 0.3 g κ-carrageenan + 1% trehalose + tween 20 + orange essential oil + glycerol |
| 0.3gTr3 | 0.3 g κ-carrageenan + 3% trehalose + glycerol |
| 0.3gTr3OT80 | 0.3 g κ-carrageenan + 3% trehalose + tween 80 + orange essential oil + glycerol |
| 0.3gTr3OT20 | 0.3 g κ-carrageenan + 3% trehalose + tween 20 + orange essential oil + glycerol |
| Sample | T356 (%) | T600 (%) | Sample | T356 (%) | T600 (%) |
|---|---|---|---|---|---|
| c | 82.20 ± 0.02 a | 88.43 ± 0.03 a | 0.3g c | 83.79 ± 0.05 a | 87.69 ± 0.02 a |
| OT80 | 7.07 ± 1.22 bdfgh | 42.06 ± 1.15 b | 0.3gOT80 | 28.23 ± 0.13 b | 87.81 ± 0.35 ac |
| OT20 | 10.81 ± 0.04 d | 84.31 ± 0.03 c | 0.3gOT20 | 11.77 ± 0.01 c | 82.14 ± 0.04 b |
| Tr0.5 | 75.52 ± 0.06 c | 80.76 ± 0.08 d | 0.3gTr0.5 | 83.63 ± 0.06 a | 87.30 ± 0.02 c |
| Tr0.5OT80 | 1.02 ± 0.13 bg | 14.56 ± 1.16 eghi | 0.3gTr0.5OT80 | 5.55 ± 0.03 d | 21.85 ± 0.03 d |
| Tr0.5OT20 | 1.54 ± 0.03 b | 8.50 ± 0.02 e | 0.3gTr0.5OT20 | 4.42 ± 0.15 e | 21.23 ± 0.27 d |
| Tr1 | 75.06 ± 0.07 e | 81.03 ± 0.04 d | 0.3gTr1 | 80.69 ± 2.68 af | 85.12 ± 2.21 abc |
| Tr1OT80 | 3.52 ± 0.73 bfgh | 21.37 ± 0.27 f | 0.3gTr1OT80 | 6.33 ± 0.05 g | 22.05 ± 0.07 d |
| Tr1OT20 | 1.88 ± 0.01 f | 10.94 ± 0.01 g | 0.3gTr1OT20 | 1.23 ± 0.01 h | 9.09 ± 0.04 e |
| Tr3 | 64.14 ± 2.21 ce | 76.06 ± 1.37 d | 0.3gTr3 | 67.61 ± 0.14 f | 69.51 ± 0.03 f |
| Tr3OT80 | 0.17 ± 0.05 h | 9.00 ± 0.02 h | 0.3gTr3OT80 | 0.61 ± 0.01 i | 3.05 ± 0.01 g |
| Tr3OT20 | 0.69 ± 0.00 g | 9.79 ± 0.03 i | 0.3gTr3OT20 | 0.14 ± 0.02 j | 1.85 ± 0.00 h |
| Sample | Transparency Value | Sample | Transparency Value |
|---|---|---|---|
| c | 23.36 ± 0.00 a | 0.3g c | 29.89 ± 0.00 a |
| OT80 | 6.86 ± 0.05 b | 0.3gOT80 | 10.41 ± 0.01 b |
| OT20 | 8.08 ± 0.00 c | 0.3gOT20 | 9.49 ± 0.00 c |
| Tr0.5 | 18.16 ± 0.00 d | 0.3gTr0.5 | 27.08 ± 0.00 d |
| Tr0.5OT80 | 4.41 ± 0.13 ei | 0.3gTr0.5OT80 | 7.80 ± 0.00 e |
| Tr0.5OT20 | 3.60 ± 0.00 f | 0.3gTr0.5OT20 | 6.86 ± 0.03 f |
| Tr1 | 15.07 ± 0.00 g | 0.3gTr1 | 21.44 ± 0.12 g |
| Tr1OT80 | 4.93 ± 0.02 e | 0.3gTr1OT80 | 6.83 ± 0.01 f |
| Tr1OT20 | 3.92 ± 0.00 i | 0.3gTr1OT20 | 4.83 ± 0.01 h |
| Tr3 | 8.12 ± 0.03 c | 0.3gTr3 | 9.96 ± 0.00 i |
| Tr3OT80 | 2.65 ± 0.00 h | 0.3gTr3OT80 | 1.59 ± 0.00 j |
| Tr3OT20 | 2.61 ± 0.00 j | 0.3gTr3OT20 | 0.77 ± 0.00 k |
| Sample | No. | Antimicrobial activity against Staphylococcus aureus subsp. aureus (MRSA) CCM 7110 | Antimicrobial activity against Escherichia coli CCM 3954 | Antimicrobial activity against Candida albicans CCM 8261 |
|---|---|---|---|---|
| c | 1C | + (2) | + (1) | + (2) |
| OT80 | 1 | + (2) | + (1) | + (1) |
| OT20 | 13 | + (1) | + (1) | + (2) |
| Tr0.5 | 2C | + (2) | + (1) | + (2) |
| Tr0.5OT80 | 2 | + (1) | + (1) | + (2) |
| Tr0.5OT20 | 14 | + (1) | + (1) | + (2) |
| Tr1 | 3C | + (1) | + (1) | + (1) |
| Tr1OT80 | 3 | + (1) | + (1) | + (1) |
| Tr1OT20 | 15 | + (1) | + (2) | + (2) |
| Tr3 | 4C | + (2) | + (1) | − (4) |
| Tr3OT80 | 4 | + (2) | + (1) | + (2) |
| Tr3OT20 | 16 | + (2) | + (1) | + (2) |
| 0.3g c | 5C | + (1) | + (2) | + (2) |
| 0.3gOT80 | 5 | + (1) | + (1) | + (2) |
| 0.3gOT20 | 17 | + (2) | + (2) | − (5) |
| 0.3gTr0.5 | 6C | + (1) | + (1) | − (5) |
| 0.3gTr0.5OT80 | 6 | + (1) | + (1) | − (3) |
| 0.3gTr0.5OT20 | 18 | + (2) | − (3) | − (3) |
| 0.3gTr1 | 7C | + (2) | − (3) | − (3) |
| 0.3gTr1OT80 | 7 | + (2) | − (5) | − (3) |
| 0.3gTr1OT20 | 19 | + (2) | − (5) | − (3) |
| 0.3gTr3 | 8C | + (2) | + (1) | − (3) |
| 0.3gTr3OT80 | 8 | − (4) | − (4) | − (4) |
| 0.3gTr3OT20 | 20 | + (2) | − (5) | − (3) |
Publisher’s Note: MDPI stays neutral with regard to jurisdictional claims in published maps and institutional affiliations. |
© 2021 by the authors. Licensee MDPI, Basel, Switzerland. This article is an open access article distributed under the terms and conditions of the Creative Commons Attribution (CC BY) license (http://creativecommons.org/licenses/by/4.0/).
Share and Cite
Simona, J.; Dani, D.; Petr, S.; Marcela, N.; Jakub, T.; Bohuslava, T. Edible Films from Carrageenan/Orange Essential Oil/Trehalose—Structure, Optical Properties, and Antimicrobial Activity. Polymers 2021, 13, 332. https://doi.org/10.3390/polym13030332
Simona J, Dani D, Petr S, Marcela N, Jakub T, Bohuslava T. Edible Films from Carrageenan/Orange Essential Oil/Trehalose—Structure, Optical Properties, and Antimicrobial Activity. Polymers. 2021; 13(3):332. https://doi.org/10.3390/polym13030332
Chicago/Turabian StyleSimona, Jancikova, Dordevic Dani, Sedlacek Petr, Nejezchlebova Marcela, Treml Jakub, and Tremlova Bohuslava. 2021. "Edible Films from Carrageenan/Orange Essential Oil/Trehalose—Structure, Optical Properties, and Antimicrobial Activity" Polymers 13, no. 3: 332. https://doi.org/10.3390/polym13030332
APA StyleSimona, J., Dani, D., Petr, S., Marcela, N., Jakub, T., & Bohuslava, T. (2021). Edible Films from Carrageenan/Orange Essential Oil/Trehalose—Structure, Optical Properties, and Antimicrobial Activity. Polymers, 13(3), 332. https://doi.org/10.3390/polym13030332

